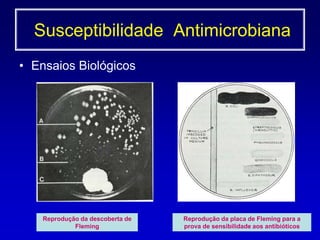
Ensaios BiológicosReprodução da descoberta de FlemingReprodução da placa de Fleming para a prova de sensibilidade aos antibióticos   Susceptibilidade  Antimicrobiana
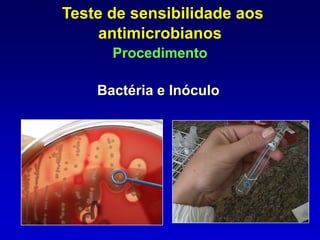
ETEST
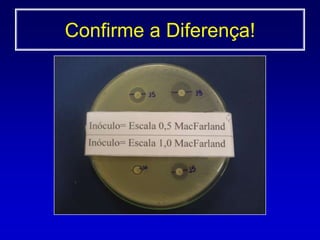
Método de crescimento0,5 McFarland 1a 2x108 UFC/mL
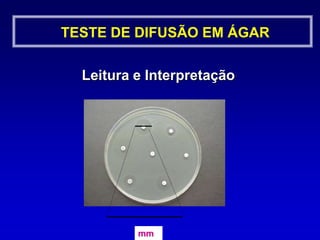
Permite crescimento satisfatório da maioria dos     patógenosTESTE DE DIFUSÃO EM ÁGARO que devemos saber sobre os meios? Umidade

[1] O documento discute métodos para detectar resistência bacteriana a antimicrobianos em laboratórios clínicos, incluindo teste de sensibilidade por difusão em ágar, diluição em caldo e métodos automatizados. [2] É importante padronizar procedimentos, meios de cultura, incubação e interpretação para assegurar resultados precisos. [3] Testes regulares de sensibilidade são essenciais para orientar terapia antimicrobiana e monitorar o surgimento de resistência.